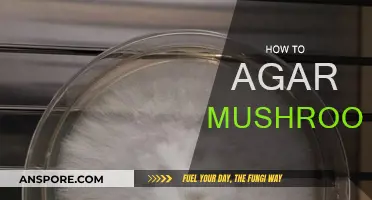
Grow Your Own Mushrooms: Agar Method

Functional mushrooms have evolved from pizza toppings and psychedelic trips to wellness panaceas. Mushroom gummies are chewable supplements infused with the power of medicinal mushrooms. They are formulated as blends of mushrooms, such as Lion's Mane and Reishi, instead of a single-origin mushroom. These gummies promise to boost your immune system, clear brain fog, and sharpen your cognitive function. However, the market is murky, with some mushroom edibles containing alarming additives, and it is challenging to figure out what is in these products.
| Characteristics | Values |
|---|---|
| Taste | Like candy |
| Target Audience | Men and women seeking premium hemp-based products |
| Ingredients | Medicinal mushrooms, bioactive compounds (beta-glucans, terpenes, polysaccharides, and antioxidants), sugar or sweeteners, nootropic ingredients, caffeine, Lion's Mane, Alpha-GPC, adaptogenic root Rhodiola, etc. |
| Effects | Boosted immune system, improved cognitive function, improved memory and learning, increased energy, stamina, strength, and mental capacity, better athletic performance, stress relief, better mood, consistent energy levels, improved sleep quality, etc. |
| Concerns | Illnesses and hospitalizations, presence of alarming additives, unregulated market, difficulty in testing |
Explore related products
What You'll Learn

The health benefits of mushroom gummies
Mushroom gummies are a convenient and tasty way to harness the health benefits of functional mushrooms. They are made using functional or adaptogenic mushrooms, which are known for their health-promoting properties and have been used in traditional medicine practices for centuries.
One of the most popular types of adaptogenic mushrooms used in these gummies is Lion's Mane, which is known for its cognitive benefits, including improved focus, memory, and nerve health. Other types include Reishi, which is celebrated for its immune-supporting properties and calming effects, and Cordyceps, which is traditionally used for energy and stamina support.
Mushroom gummies are said to provide a range of health benefits, including improved cognitive function, enhanced energy levels, better mood, and reduced stress. They are also believed to support overall wellness by helping the body adapt to various forms of physical, chemical, or biological stress.
Some people have reported positive experiences with mushroom gummies, claiming increased energy, improved focus, and better stress management. However, it is important to note that individual results may vary, and scientific research is still ongoing to understand the full scope of their benefits.
While the health benefits of mushroom gummies are promising, it is crucial to approach them with caution. The market for these products is largely unregulated, and some brands have been found to contain additives that may be harmful. It is always advisable to consult a healthcare professional before incorporating any new supplement into your routine.
Anthrax and Mushrooms: What's the Real Connection?
You may want to see also

The potential dangers of mushroom edibles
Mushroom edibles are making people sick, and scientists are still unsure of the exact cause. However, testing has revealed that some mushroom edibles contain alarming additives, including unlabelled and potentially harmful substances. These substances include psilocybin, a Schedule I substance believed by the Drug Enforcement Administration (DEA) to have a high potential for abuse and no legitimate medical purpose. Psilocybin is a hallucinogenic chemical found in certain mushrooms known as magic mushrooms, which can cause euphoria and hallucinations. Other additives found in mushroom edibles include psilocin, ephedrine, and kratom, which has opioid-like properties.
The effects of psilocybin vary widely, and adverse side effects can range from mild to moderate, sometimes requiring medical treatment. Disturbing hallucinations, anxiety, and panic may occur, along with persistent distressing alterations in perception. Additionally, there is a risk of accidental poisoning from consuming the wrong types of mushrooms, with symptoms including muscle spasms, confusion, and delirium.
The market for mushroom edibles is growing, and they are often sold online, in smoke shops, and convenience stores. They are marketed with claims of health benefits such as improved cognitive function, stress relief, better mood, and increased energy levels. However, these products might contain undisclosed ingredients and have been linked to severe illnesses and even suspected deaths.
It is important for consumers to be aware of the potential risks associated with mushroom edibles and to seek immediate medical attention if they experience any adverse symptoms. While mushrooms may have legitimate benefits, it is crucial to approach mushroom supplements with caution due to the potential presence of undisclosed and harmful additives.
White Mushrooms and Gas: What's the Link?
You may want to see also

The appeal of mushroom gummies
For those seeking to incorporate the benefits of medicinal mushrooms into their daily routines, mushroom gummies offer a convenient and tasty solution. Unlike bitter powders or capsules, these gummies are chewable supplements that combine the natural goodness of mushrooms with a palatable and enjoyable form. They taste more like candy and your childhood than a dietary supplement, making it easier to incorporate mushrooms into your wellness routine.
Mushroom gummies are formulated as blends of different mushroom species, each showcasing the unique properties of the fungi. The mushrooms used are often cultivated using specific processes and grown in controlled environments to ensure quality and potency. The gummies may be certified organic, non-GMO, gluten-free, and kosher, making them suitable for a wide range of diets and lifestyles.
The functional mushrooms in these gummies are rich in various bioactive compounds, including beta-glucans, terpenes, polysaccharides, and antioxidants. These compounds are readily absorbed by the body and interact with various systems, such as the immune system, nervous system, and cellular processes. They are believed to provide a range of benefits, including enhanced cognitive function, improved stress response, and boosted immune function.
Some specific mushroom species commonly found in gummies include Lion's Mane, Reishi, Chaga, and Cordyceps. Lion's Mane, for example, is known for improving focus and memory, while Reishi has adaptogenic properties that may help the body adapt to stress and promote relaxation.
While the potential health benefits of mushroom gummies are appealing, it is important to exercise caution. Some mushroom edibles have been found to contain alarming additives, and there have been reports of people getting sick from consuming them. It is crucial to do your research, buy from reputable sources, and be aware of any potential risks associated with these products.
Foraging Mushrooms: Picking the Right Ones
You may want to see also
Explore related products

The best mushroom gummies on the market
Mushroom gummies have become increasingly popular as functional fungi have been gummified, promising to boost your immune system, clear brain fog, and sharpen cognitive function. However, it's important to exercise caution when consuming mushroom edibles as some have been found to contain alarming additives, causing a wave of illnesses.
Plant People's WonderDay Gummies
Plant People's WonderDay Gummies are sugar-free, vegan, non-GMO, and allergen-free. They are made with a blend of eight functional mushrooms, including royal sun, lion's mane, and turkey tail, and are raspberry-flavoured. The mushrooms are grown in the United States, primarily in the Rocky Mountains, using regenerative practices. Plant People offers trial packs, allowing you to sample the product without committing to a full bag.
Om's Master Blend Mushroom Gummies
Om's Master Blend Mushroom Gummies stand out for their rigorous sourcing and transparency. They utilise the entire mushroom, including the mycelium, primordia, and fruiting body, providing consumers with a full range of bioactive compounds such as beta-glucans, polyphenols, and prebiotic fibres. Each gummy contains a blend of 10 functional mushroom species, including lion's mane, cordyceps, and reishi.
Auri's Super Mushroom Focus Gummies
Auri's Super Mushroom Focus Gummies claim a more than 90% absorption rate and offer a 60-day money-back guarantee. In addition to lion's mane, these gummies contain alpha-GPC and adaptogenic root rhodiola, which are known to improve brain health, increase energy, and manage depression and anxiety. Positive customer reviews highlight the noticeable difference in energy and focus, as well as the tasty berry flavour.
Fungies Multi Mushroom Gummies
Fungies Multi Mushroom Gummies combine the sweetness of ripe strawberries, juicy blueberries, and a hint of black currant for a delicious experience. They are formulated with functional mushrooms like Reishi, Turkey Tail, and Maitake, which are known to support immunity, gut health, and overall wellness. Fungies offers a 100% satisfaction guarantee and a refund policy for new customers who are not fully satisfied with their purchase.
While these products offer a convenient way to incorporate the benefits of functional mushrooms into your daily routine, it is always important to do your research, consult experts, and be cautious of potential additives or unregulated substances.
Mushrooms: A Low-Protein Superfood?
You may want to see also

The effects of magic mushroom gummies
Magic mushroom gummies are a growing trend in the wellness industry, with many companies advertising them as a natural remedy for various ailments. These gummies are made from functional fungi and are said to offer benefits such as improved cognitive function, energy boosts, and stress relief. However, the effects of magic mushroom gummies are complex and vary depending on the type of mushroom and the individual's biology.
Magic mushroom gummies typically contain a blend of mushroom species, such as lion's mane, cordyceps, and reishi. These mushrooms are believed to have beneficial effects on brain health, memory, and energy levels. For example, lion's mane is known for its potential to improve focus and enhance memory retention. Some gummies also contain additional ingredients like Alpha-GPC and adaptogenic roots, which are intended to boost energy and mental capacity while reducing anxiety and depression.
While the potential benefits of magic mushroom gummies are touted by many, there are also risks associated with their consumption. The lack of regulation in the industry has led to instances of harmful additives and unlabeled substances in these products. Some gummies have been found to contain toxic levels of muscimol, a dangerous agonist for the GABA receptor that causes intense depressant effects. Psilocybin, psilocin, ephedrine, and kratom have also been detected in certain gummies, posing serious health risks to unsuspecting consumers.
It is always advisable to exercise caution when consuming magic mushroom gummies or any other substance with potential psychological effects. Given the unregulated nature of this industry, consumers must be vigilant about the potential risks and side effects. While functional mushrooms can offer benefits, it is crucial to purchase from reputable sources and be aware of the potential presence of harmful additives or unlabeled substances.
Mushrooms and Fever Blisters: A Connection?
You may want to see also
Frequently asked questions
Mushroom gummies are chewable supplements infused with the power of medicinal mushrooms. They combine the natural goodness of mushrooms with a convenient and tasty form, making them an attractive option for those seeking holistic wellness.
Mushroom gummies are believed to support immune function, promote relaxation, improve sleep quality, enhance cognitive function, and provide antioxidant support, among other potential benefits.
While mushroom gummies are marketed as having healing and therapeutic properties, there have been reports of people falling sick after consuming them. Scientists are still unsure of the exact reasons, but some believe it could be due to the presence of alarming additives or toxic compounds in the gummies.